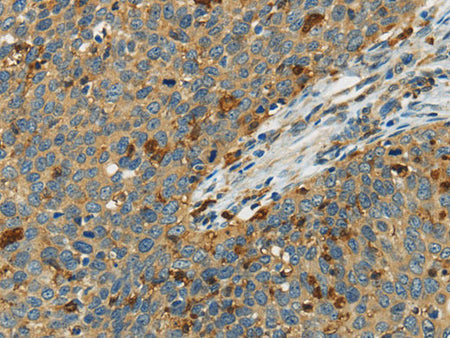
AIF1 Polyclonal Antibody Store at -20°C
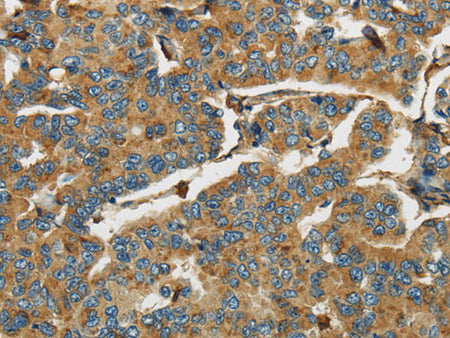
AIF1 Polyclonal Antibody Store at -20°C

AIF1 Polyclonal Antibody Store at -20°C
Couldn't load pickup availability

Still have questions? Ask our experts!
AIF1 Polyclonal Antibody Store at -20°C
| SKU # | E-AB-10382 |
| Reactivity | Human, Mouse, Rat |
| Host | Rabbit |
| Applications | WB, IHC |
Product Details
| Isotype | IgG |
| Host | Rabbit |
| Reactivity | Human, Mouse, Rat |
| Applications | WB, IHC |
| Clonality | Polyclonal |
| Immunogen | Recombinant protein of human AIF1 |
| Abbre | AIF1 |
| Synonyms | AIF 1, AIF-1, AIF1, AIF1 protein, Aif1, Allograft inflammatory factor 1, Allograft inflammatory factor 1 splice variant G, BART 1, G1, G1 putative splice variant of , allograft inflammatory factor-1 splice variant Hara-1, balloon angioplasty responsive transcription |
| Swissprot | |
| Calculated MW | 17 kDa |
| Cellular Localization | Cytoplasm>cytoskeleton. Cell projection>ruffle membrane. Associated with the actin cytoskeleton at membrane ruffles and at sites of phagocytosis. |
| Concentration | 0.6 mg/mL |
| Buffer | Phosphate buffered solution, pH 7.4, containing 0.05% stabilizer and 50% glycerol. |
| Purification Method | Affinity purification |
| Research Areas | Cancer, Cell Biology, Metabolism, Immunology, Neuroscience |
| Conjugation | Unconjugated |
| Storage | Store at -20°C Valid for 12 months. Avoid freeze / thaw cycles. |
| Shipping | The product is shipped with ice pack,upon receipt,store it immediately at the temperature recommended. |
Related Reagents
| Applications | Recommended Dilution |
| WB | 1:200-1:1000 |
| IHC | 1:50-1:200 |
Background
This gene is induced by cytokines and interferon.Its protein product is thought to be involved in negative regulation of growth of vascular smooth muscle cells, which contributes to the anti-inflammatory response to vessel wall trauma.Three transcript variants encoding different isoforms have been found for this gene.Actin-binding protein that enhances membrane ruffling and RAC activation.Enhances the actin-bundling activity of LCP1.Binds calcium.Plays a role in RAC signaling and in phagocytosis.May play a role in macrophage activation and function.Promotes the proliferation of vascular smooth muscle cells and of T-lymphocytes.Enhances lymphocyte migration.Plays a role in vascular inflammation.